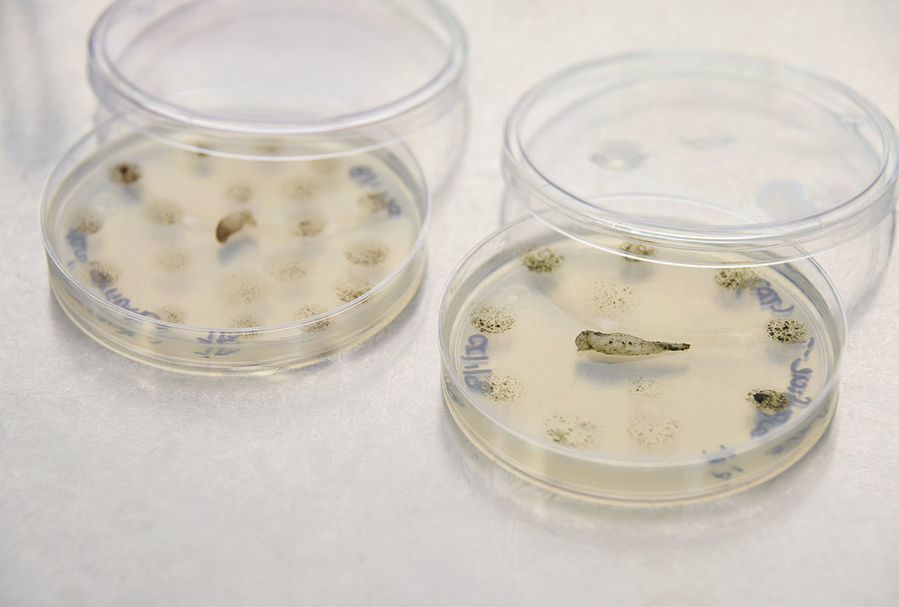

El Ministerio de Salud de Costa Rica giró instrucciones a los establecimientos que contengan aguas termales en el país para advertir y prevenir a los usuarios de convertirse en un nuevo caso de infección por Naegleria fowleri, conocida popularmente como la "ameba comecerebros", ya que la enfermedad que causa se traduce en inflamación del cerebro y destrucción de tejido cerebral.
Según informó la institución, a raíz del caso reportado en enero en una persona menor de edad que lamentablemente falleció, y al cual se suma un nuevo caso confirmado la semana pasada de una niña de cuatro años -quien evoluciona bien de salud-, se optó por emitir lineamientos para ese tipo de establecimientos.
"Bajo el principio precautorio, el Ministerio de Salud emitirá una modificación al reglamento de manejo de piscinas con el fin de incluir un apartado específico de regulaciones para aguas termales naturales. Las nuevas medidas para dichos establecimientos incluyen rotulación de advertencia sobre el riesgo de meningitis amebiana como prohibición de toboganes o trampolines que descarguen en aguas termales naturales", detalló la institución en un comunicado.
Para la entidad, la aplicación de estas medidas es urgente con el fin de prevenir el riesgo de salud pública ante la posible presencia de amebas en las aguas termales naturales.
"La menor visitó aguas termales en la provincia de Alajuela el pasado sábado e inició desde el lunes con [dolores de cabeza], vómito y fiebre. La niña está reaccionando de manera positiva al tratamiento administrado", afirmó la institución. Los tres casos de Naegleria fowleri registrados en la historia del país han sido en menores de edad.
Las nuevas regulaciones se impulsarán mediante la emisión de órdenes sanitarias, las cuales son de acatamiento obligatorio. Además de prohibir toboganes o trampolines que descarguen en piscinas de origen termal natural, el Ministerio de Salud exigirá superficies que favorezcan la limpieza y la entubación de la extracción del agua termal.
"Además con la nueva regulación de aguas termales naturales será necesario que los administraciones de instalaciones de piscinas con aguas termales naturales, coloquen rótulos visibles en la entrada principal, parqueos, vestidores y cada piscina con la siguiente advertencia:
Mantenga su cabeza fuera del agua. Prevenga la meningitis amebiana. No se sumerja, ni arroje agua a otras personas.
Los administradores también estarán obligados a realizar la advertencia verbal a personas con discapacidad visual.